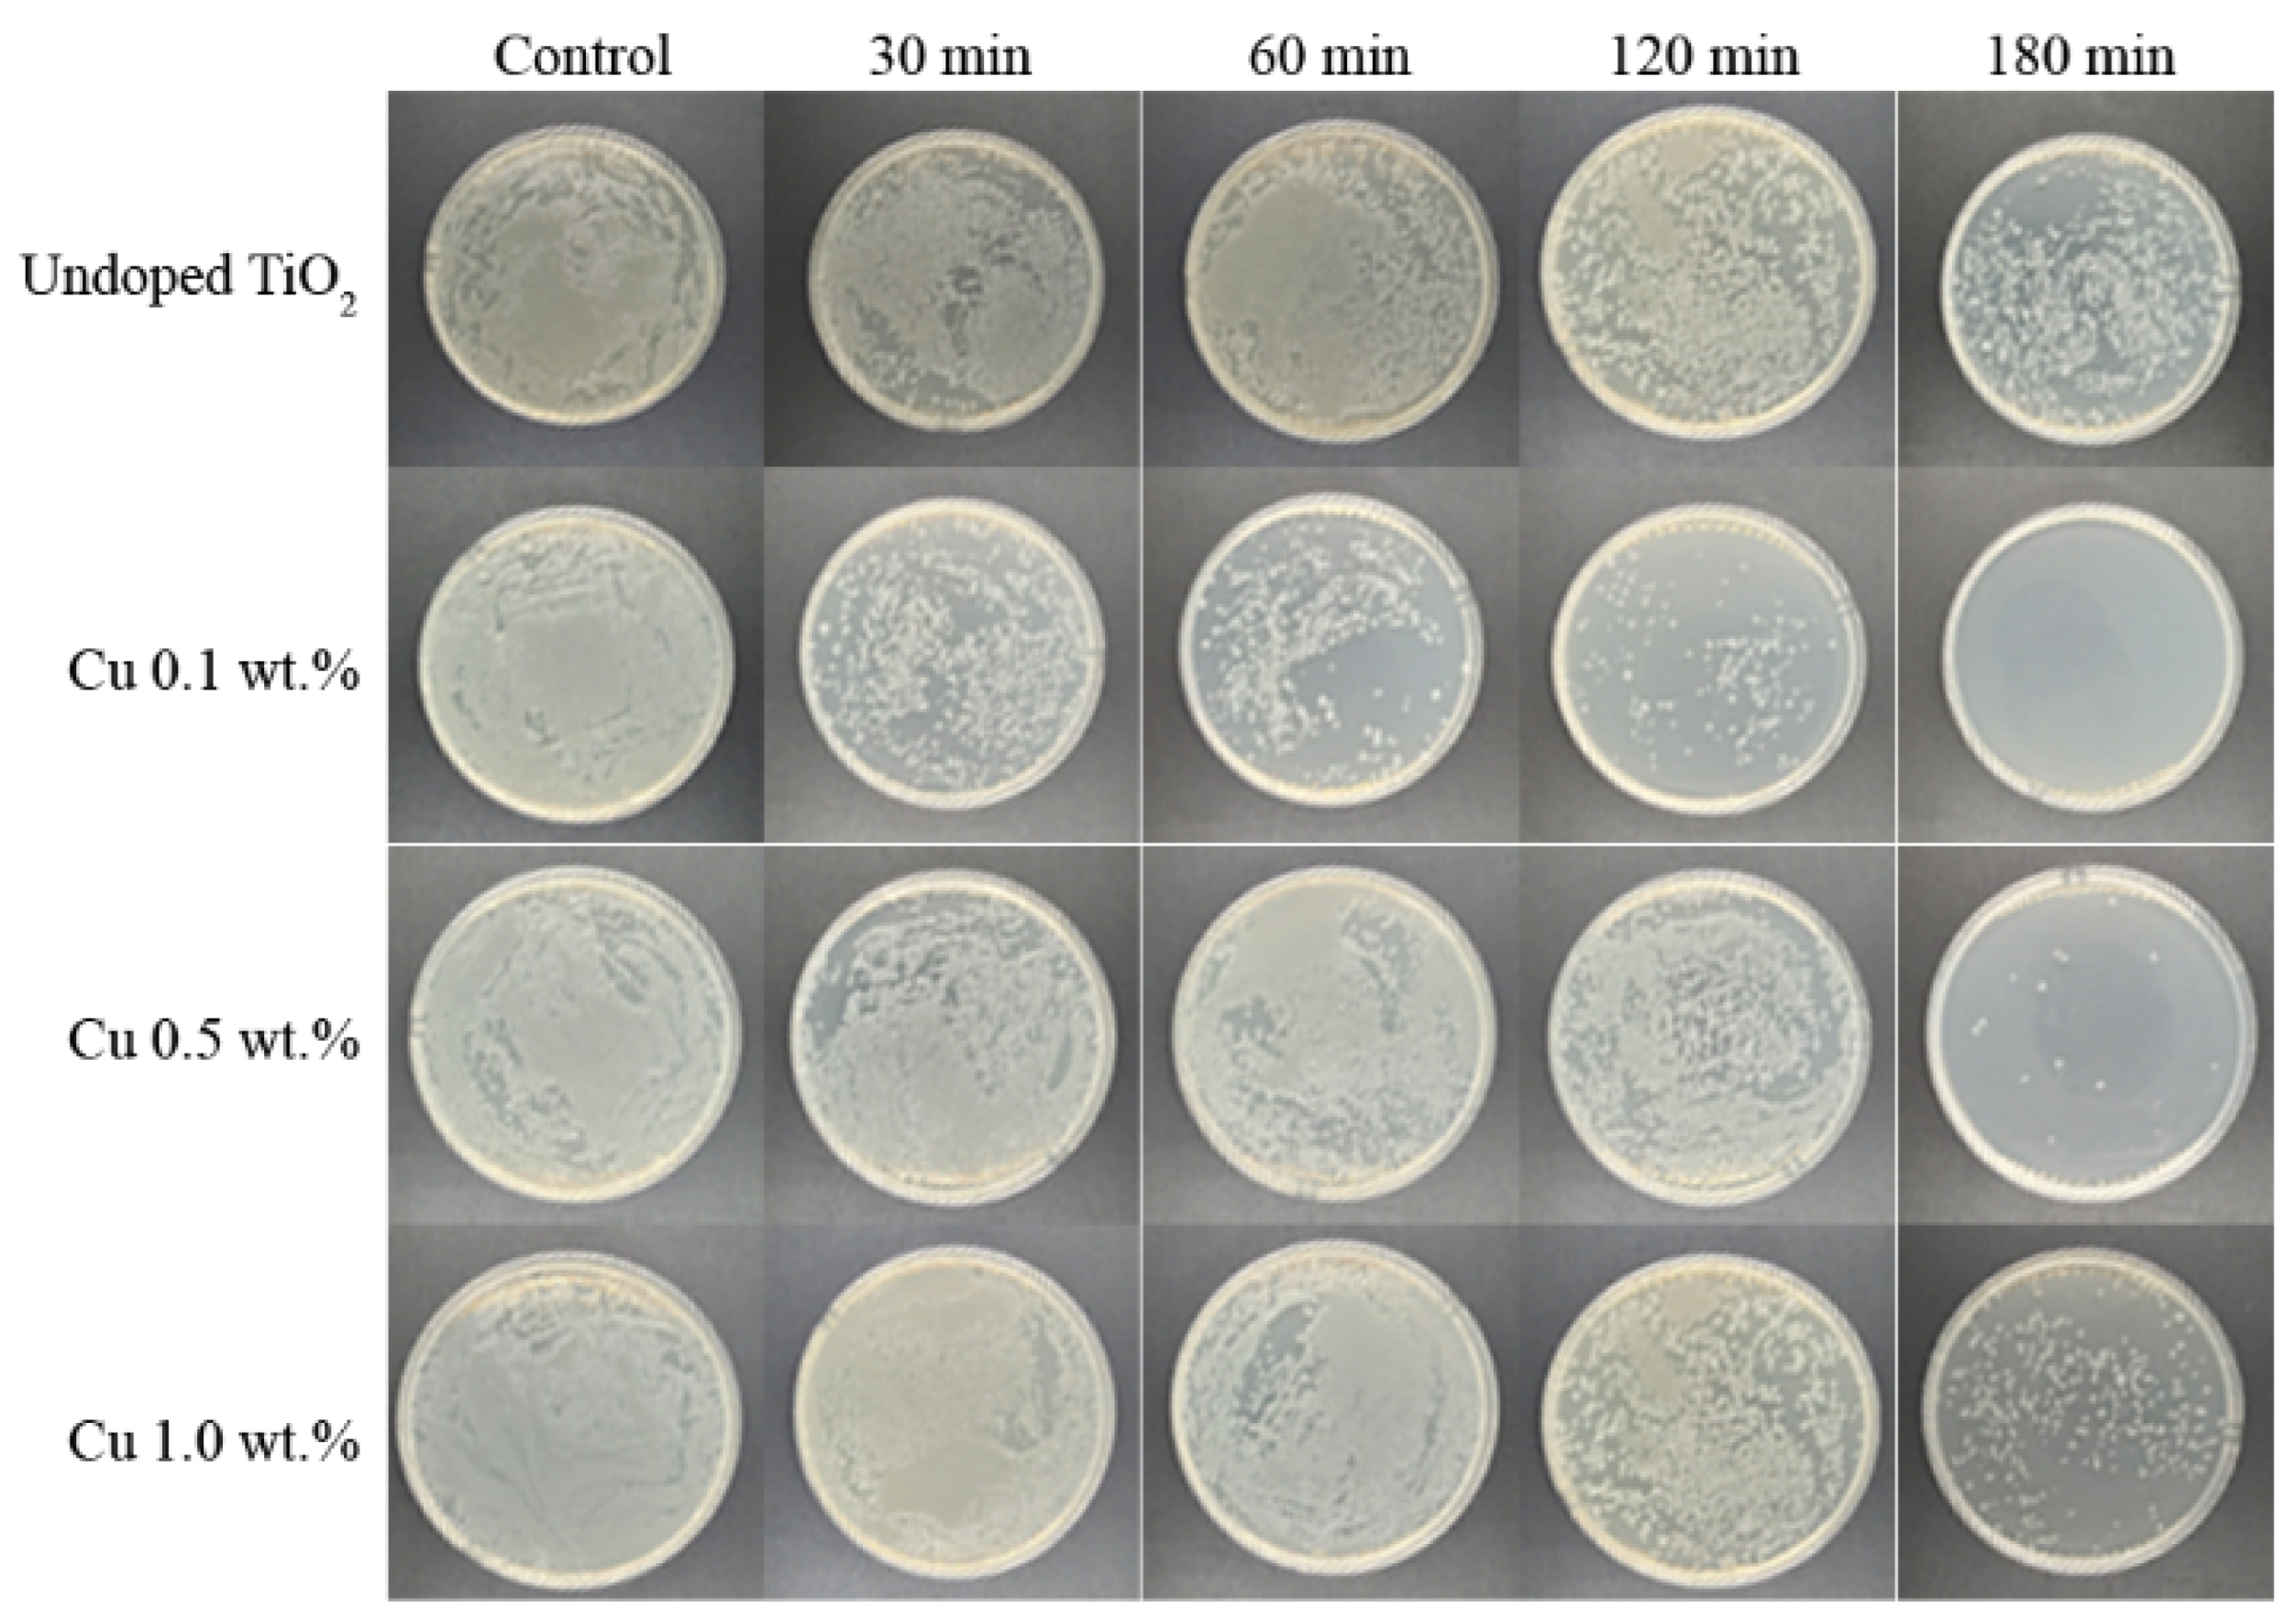
Nanomaterials 12 01198 g007

Abstract
In this work, metal-doped titanium dioxide (TiO2) was synthesised with the aim of improving photocatalytic degradation and antimicrobial activities; TiO2 was doped with copper (Cu) ranging from 0.1 to 1.0 wt%. The physical and chemical properties of the Cu-doped TiO2 nanoparticles were characterized by X-ray diffraction (XRD), transmission electron microscopy (TEM), the Brunauer–Emmett–Teller method (BET) and diffuse reflection spectroscopy (DRS). The results revealed that the anatase phase of TiO2 was maintained well in all the Cu-doped TiO2 samples. No significant difference in the particle sizes or the specific surface areas was caused by increasing Cu doping. However, the band gap decreased continuously from 3.20 eV for undoped TiO2 to 3.12 eV for 1.0 wt.% Cu-doped TiO2. In addition, the 0.1 wt.% Cu-doped TiO2 displayed a much greater photocatalytic degradation of methylene blue (MB) and excellent antibacterial ability for Escherichia coli (E. coli) compared to undoped TiO2. On the other hand, the high Cu doping levels had negative impacts on the surface charge of nanoparticles and charge transfer for OH• generation, resulting in decreasing MB degradation and E. coli photokilling for 1.0 wt.% Cu-doped TiO2.
1. Introduction
Over the past several decades, the use of titanium dioxide (TiO2, titania) has been increasing significantly due to its advantages and capabilities for various applications, including the antibacterial disinfection of surfaces, self-cleaning and self-sterilization, site remediation, domestic and industrial wastewater treatments [1,2,3]. In addition, TiO2 is highly chemically-stable and human-friendly [4,5], therefore, it can also be used for biomaterials, biomedical devices and food applications [6,7]. It must be noted that TiO2 nanoparticles are considered safe: they are used as food additives and for surface coating materials [8,9]. Their safety has been investigated using a model intestinal bacterial community, indicating that TiO2 does not significantly alter the human gut microbiome [9]. Theoretically, TiO2 has a band gap of 3.20 eV, which means the photocatalytic activity can be activated only under UV regions. Therefore, reducing the TiO2 band gap is one of the main goals of researchers in the field, because it can enhance the photocatalytic activity under visible light regions.
Various narrow-band-gap materials such as cerium dioxide (CeO2) and bismuth vanadate (BiVO4) are active under visible light and exhibit promising photocatalytic activity in the degradation of organic compounds. The redox potential of Ce4+/Ce3+ makes it a particularly effective photocatalyst of CeO2, yet the wide band gap range of 2.6 to 3.4 eV, depending on the preparation methods, limits the applications of CeO2, though it can adsorb a larger fraction of the solar spectrum rather than TiO2 [10]. Conversely, BiVO4 has a relatively small band gap of ~2.4 eV and its high photocatalytic activity under visible light has attracted attention to its use as a photocatalyst. However, low photocatalytic activity of BiVO4 has been observed due to its weak adsorption performance and poor migration of charged carriers [11].
There are several methods of reducing the band gap of TiO2, but one of the most well-known methods involves doping with transition metals. Many metals have been introduced for this purpose, such as Mn [12], Co [13], Zn [14] and Cu [15]. The latter has several significant advantages; for example, Cu can create multi-bands, act as inhibitor of grain growth and extend the electron-hole (e−, h+) pair recombination. In addition, an improvement in the visible light adsorption of TiO2 was observed after doping with Cu, resulting in the further promotion of photocatalytic efficiency [16]. Leading research has further shown that Cu-doped TiO2 provided superior antibacterial performance [17,18,19,20,21,22,23,24]. These studies proved that Cu-doped TiO2 can be active under UV-A and visible light, and also that it can kill 100% of microbes. In addition, Cu has also been used in various forms of TiO2, for example, deposited on the top layer of TiO2 thin film [25], nanocomposite forms of CuO-TiO2 [26] and grafting Cu2+ in TiO2 and WO2 structures [27]. The well-known synthesis method of Cu-doped TiO2 nanoparticles is the sol-gel technique; the nanoparticles are calcined at high temperatures ranging from 500 to 700 °C [16,28], and Cu precursors, such as copper chloride (CuCl2) and copper sulphate (CuSO4), are added to the titanium solution. The precipitation method has also been used to synthesise the Cu-doped nanocrystalline TiO2; this method can be carried out using low-cost materials and easier manufacturing methods at industrial levels. Another attractive hydrothermal method, employed under self-produced pressures at low temperatures, can produce highly homogeneous nanoparticles with fewer contamination phases and less particle agglomeration [29,30]. Among the above-mentioned techniques, the hydrothermal method is very interesting due to its significant advantages: it makes it easy to obtain nanostructured morphology, a variation in the synthesis method can be implemented to enhance the properties of TiO2, and it is a feasible method for varying applications.
Furthermore, TiO2-based composites have been synthesised to improve material properties, photocatalytic activity and degradation of organic compounds. The graphene–TiO2 composite can produce a large number of pores, which increases the active photocatalytic sites and provides space for adsorption [31]. This composite also showed efficient degradation of pollutants under both visible light and sunlight [31]. Another composite of Zeolite Socony Mobil-5 (ZSM-5) and TiO2 displayed great surface area and mesopore volume. However, the synthesis method of the ZSM-5/TiO2 composite affected material properties and pollutant degradation [32].
Although the Cu-doped TiO2 is well-recognized for antibacterial performance, the doping ratio of Cu/Ti is still doubtful at present. The doping percentage can be found over the range of 0.1 up to 10.0 wt.%. In this work, we have succeeded in discovering the best Cu doping weight percentage that could provide the best photokilling efficiency. In addition, a one-step process of a hydrothermal method has been demonstrated in the present work for synthesising various weight percentages of Cu-doped TiO2 nanoparticles. These nanoparticles were also characterised in physical and chemical properties, including the structure, topology and band gap energy. In addition, the improved photocatalytic and antibacterial abilities of Cu-doped TiO2 nanoparticles were examined and discussed in comparison to undoped TiO2.
2. Experimental Procedure
2.1. Cu-Doped TiO2 Nanoparticle Synthesis
Undoped and Cu-doped TiO2 nanoparticles were synthesised using hydrothermal methods. A 4 mL volume of titanium (IV) isopropoxide (TTIP: 97% reagent grade, Sigma-Aldrich) and 20 mL of ethanol (>99% reagent grade, Merck) were mixed, and then 4 mL of deionized (DI) water was slowly added to the solution. After stirring at 200 rpm for 1 h at room temperature (~25 °C), the solution was transferred to a Teflon-lined stainless steel autoclave and heated at 180 °C for 12 h. Finally, the TiO2 nanoparticles were washed with DI water and dried at 100 °C for 12 h. For Cu-doped TiO2 nanoparticles, various weight percentages of Cu, including 0.1, 0.5 and 1.0 wt.% of the aqueous solution, were prepared by dissolving CuSO4·5H2O (>98% reagent grade, Merck) in 100 mL of DI water. The Cu solution was added to the titanium solution during the stirring. The mixed solution was transferred to a Teflon-lined stainless steel autoclave, and the same procedure as for TiO2 nanoparticle preparation was followed.
2.2. Characterisation of Nanoparticles
The structural properties and phase identification of nanoparticles were examined using X-ray diffraction (XRD: Bruker, D2 Phaser) under Cu Kα radiation (λ = 0.154 nm) and 2θ ranging from 20° to 80°. The topological properties of nanoparticles were investigated using a transmission electron microscope (TEM: JEOL, JEM-2100Plus; Japan) with an acceleration voltage of 100 kV. In addition, the specific surface area of nanoparticles (SSA) was obtained with the Brunauer–Emmett–Teller method (BET: Micromeritics, TriStar-II-3020) using nitrogen adsorption-desorption analysis at 77 K. Furthermore, the optical band gap of nanoparticles was determined using diffuse reflection spectroscopy (DRS: Shimadzu, UV-360) with an integrating sphere attachment (ISR-3100, Shimadzu; Japan). The band gap energy was calculated using a Tauc plot from the DRS spectrum [33].
2.3. Photocatalysis and Photokilling Examinations
Photodegradation of methylene blue (MB) was used to evaluate the photocatalytic activity of undoped and Cu-doped TiO2 nanoparticles. A 10−5 M MB concentration (~3.2 mg/L) was prepared in DI water. The undoped and Cu-doped TiO2 nanoparticles were dispersed in the MB solution at a 1 g/L concentration. Meanwhile, the MB removal efficiency using synthesised nanoparticles was compared to that of Degussa P25 (≥99.5% trace metals basis, Sigma-Aldrich), which is a well-known benchmark TiO2 with high photocatalytic efficiency. The MB solutions with nanoparticles were kept in the dark for 30 min at room temperature, and afterwards, they were radiated with UV-A (365 nm, single wavelength) with magnetic stirring at 100 rpm. The remaining MB concentration was measured with UV-VIS spectroscopy (UV-6100, Mapada; China), and the MB removal efficiency was calculated.
Gram-negative bacteria, Escherichia coli (E. coli) TISTR117 (from Thailand Institute of Scientific and Technological Research), were used as indicator strains for a photokilling evaluation of nanoparticles. The indicator strain was grown in nutrient broth at 30 °C for 16–18 h, and afterwards, the bacteria culture was diluted in DI water to obtain the initial concentration of 107 CFU/mL. The 10 mL bacterial suspensions were individually treated with 0.025 g of undoped TiO2 and 0.1 wt.%, 0.5 wt.% and 1.0 wt.% Cu-doped TiO2. It must be noted that the untreated sample (without nanoparticles) represented the control in this study. The treated samples and untreated sample were activated under 10 W of UV-A for 0, 30, 60, 120 and 180 min on the rotary platform. The layout and configuration of the experiment are presented in Figure 1. The visible cell growth was monitored by plating 100 μL of treated and untreated samples on the nutrient agar in chronological order and incubating them at 30 °C for 24 h. The number of visible colonies were counted and the bacteria viability was determined by plotting log of visible counts (CFU/mL) against incubation time under UV-A radiation.
Figure 1.
The layout of the photo-killing experimental setup.
3. Results and Discussions
Figure 2 shows the XRD patterns of undoped and Cu-doped TiO2 nanoparticles. It can be seen that undoped TiO2 consisted of two phases: anatase, as a major phase, and brookite, as a minor phase. On the other hand, Cu-doped nanoparticles contained only the sole phase of anatase. The data also indicate that as doping increased, the degree of crystallinity also increased; the reason is that Cu is known as a promoter in the grain growth structure, so it can help to promote the anatase structure [34]. The lattice parameter data and crystallite size were calculated using XRD data, and the results are presented in Table 1. The lattice parameter data suggest that the unit cell is slightly shirked with increasing Cu doping levels. This is due to the replacement of the Ti4+ with the Cu2+. Since the ionic radius of Ti is 0.61 Å and of Cu is 0.57 Å [35], the unit cell will be compressed. The crystallite size data were also similar to the data from the TEM image (7–10 nm). Therefore, these nanoparticles form a single grain particle.
Figure 2.
XRD patterns of Cu-doped TiO2 nanoparticles, Anatase: ICCD card no. 00-064-0863, Brookite: ICCD card no. 01-071-4943.
Table 1.
Summary of analytical data.
TEM images of the nanoparticles are presented in Figure 3. The undoped TiO2 nanoparticles had consistent particle sizes of 10 nm. Meanwhile, the Cu-doped TiO2 nanoparticles tended to show similar particle sizes to the undoped TiO2 nanoparticles at 10 nm. In addition, the SSA data are given in Table 1. The data reveal that the SSA of all the samples was in the same range of 180–182 m2/g. Generally, the photocatalytic performance depends on three key parameters: the optical band gap, specific surface area and electron–hole recombination rate. Since the SSA of all the samples was similar, the photocatalytic performance would rely on the optical band gap and electron-hole recombination rate. Both parameters are discussed below.
Figure 3.
TEM images of (a) undoped, (b) 0.1 wt.%, (c) 0.5 wt.% and (d) 1.0 wt.% Cu-doped TiO2 nanoparticles.
According to the structure of Cu-doped TiO2 nanoparticles, the substitution of Ti(IV) by Cu(II) was inconsistent due to the difference between ionic radii (Ti(IV) = 0.61 Å and Cu(II) = 0.57 Å) [35]. However, the smaller Cu(II) was simply replaced with the host of larger Ti(IV) in the Cu-doped TiO2 nanoparticles, causing the compression of the unit cell. To explain the charge balance of Cu-doped TiO2 on the electronic structures, band gap and band edge positions; doping elements of Cu2+ into TiO2 induces effective charges in solid state compounds. When the Cu2+ replaces Ti4+ in the TiO2 lattice, the system must be compensated by either cation vacancies or free electrons, or changed of valence state of Ti4+ ions. It is important to understand how the additional charges can affect the system and the subsequent influence on the band gap transitions. In this case, the forms of the charge-balance structures of Cu-doped TiO2 lead to the decreasing of the optical band gap, as showing Figure 4.
Figure 4.
Reflection spectra (a) and Tauc plot (b) of Cu-doped TiO2 nanoparticles.
According to the Tauc plot [33], the result revealed that the band gap was reduced by increasing Cu doping levels, as shown in Figure 4. This is because the Cu2+ ions generated sub-bands near conduction band, resulting in the band gap reduction of Cu-doped TiO2. Concurrently, the sub-bands also increased the electron-hole recombination time. These two phenomena increased the performance of photocatalytic efficiency, as shown in the MB degradation test presented in Figure 5.
Figure 5.
Photocatalytic activity of undoped and Cu-doped TiO2 nanoparticles for methylene blue (MB) degradation.
The photocatalytic performance of nanoparticles was evaluated by measuring the degradation of MB and the photokilling of E. coli. As shown in Figure 5, the results clearly indicate that Cu doping can increase the MB degradation of TiO2 nanoparticles. It is important to note that the undoped TiO2 and benchmark TiO2 (P25) achieved only ~20% of MB removal in the dark adsorption, whereas the Cu-doped TiO2 nanoparticles achieved ~40 of MB removal. Due to the similar SSA and particle sizes of undoped and Cu-doped TiO2, the surface charge of the Cu-doped TiO2 possibly caused the improvement in the MB adsorption ability. As reported in the literature [36], the pH of TiO2, of which the zeta potential shifted to zero (point of zero charge, PZC), was approximately 6.5. The PZC tended to move towards the lower pH when the Cu doping was increased: it was approximately 6.0 for 0.15 wt.% Cu-doped TiO2. The pH value of the initial MB solution was measured to be 6.2, which was above the PZC of Cu-doped TiO2. Therefore, the surface charge of nanoparticles was negative. The cationic MB dye with a positive charge favoured the electrostatic interaction with the negatively charge surface of Cu-doped TiO2 nanoparticles. This phenomenon leaded to the increase in adsorption ability in the dark as well as the MB degradation rate under UV-A irradiation.
Under UV-A irradiation, the 0.1 wt.% Cu-doped TiO2 nanoparticles demonstrated very high performance, similar to that of P25, in terms of MB degradation. Since the Cu atoms generated sub-bands in the Cu-doped TiO2 structure, this may have caused the decrease in the optical band gap [20] in this work (as shown in Table 1 and Figure 4). The sub-bands can trap the exited electron from the exited state, resulting in the slow electron-hole recombination [18] and increasing the chances of hydroxyl radical (HO•) generation [37]. Furthermore, hydrogen peroxide (H2O2) is the intermediate pathway of the photocatalytic process and can react with Cu2+ ions and generate a Fenton-like reaction to degrade MB. The hybrid process of the Fenton-like reaction and photocatalysis of using 0.1 wt.% Cu-doped TiO2 nanoparticles significantly improves the MB degradation.
On the other hand, the ion doping also acts as an impurity that creates structural defects, which negatively affects the photocatalytic performance [21]. Since the defects can trap and/or quench the excited electron and hole, the high Cu content of Cu-doped TiO2 nanoparticles makes it the recombination centre for photogenerated electron-hole pairs [38,39]. It is also interesting to consider that at the high dopant concentration, the charge trapping is high and the charge carrier pairs may recombine though quantum tunnelling [40]. In this work, the MB removal efficiency decreased to 95.83% and 92.17% for 0.5 wt.% and 1.0 wt.% Cu-doped TiO2, respectively.
The photocatalytic performance of nanoparticles was clarified by the photokilling activity of undoped and Cu-doped TiO2 nanoparticles against E. coli. Figure 6 and Figure 7 clearly present that in the control sample (the bacterial culture without nanoparticles), the UV-A irradiation did not cause any bacteria death, as shown by the steady growth curve over the incubation time. A decreasing curve of the visible bacteria count was observed in the bacterial culture with either undoped or Cu-doped TiO2 nanoparticles, meaning that both undoped and Cu-doped TiO2 nanoparticles showed antibacterial and bactericidal activities. The indicator strain was completely killed in 180 min for the 0.1 wt.% Cu-doped TiO2 nanoparticles, whereas the undoped TiO2 showed a slight inhibition of bacterial growth. In addition, the higher Cu doping of 0.5 wt.% and 1.0 wt.% Cu-doped TiO2 nanoparticles achieved lower E. coli photokilling than the 0.1 wt.% Cu-doped TiO2 nanoparticles. Furthermore, some visible bacteria growth was observed after 180 min of UV-A irradiation. It can therefore be concluded that the photokilling activity of TiO2 nanoparticles can be enhanced by doping Cu into TiO2 nanoparticles; however, its photokilling activity did not follow in a dose-dependent manner. The high Cu doping levels had negative impacts on photocatalytic performance, including MB degradation and photokilling activity, as explained above. It has to be noted that Cu-doped TiO2 can perform the photokilling activity under dark conditions with less efficiency compared to under UV irradiation [41,42,43].
Figure 6.
Antibacterial activity of undoped and Cu-doped TiO2 nanoparticles.
Figure 7.
Photo of visible E. coli colony after UV-A radiation.
Cu-doped TiO2 can perform some photokilling in dark conditions. The antibacterial property of CuO, Cu and Cu-doped TiO2 demonstrates the high performance of killing bacteria without any radiation. The UV radiation enhanced the electron transfer and the ROS generation against bacteria cells, resulting in inactivation of bacteria cells. However, it needs to be noted that the antibacterial activity of CuO-doped TiO2 nanomaterial was not investigated in our study. The cooperative effect of CuO and TiOs in CuO-doped TiO2 nanoparticles was our main interest.
According to this work, the 0.1 wt.%. Cu-doped TiO2 nanoparticles showed the best antibacterial activity. The antibacterial mechanism of TiO2 has been explained in previous studies [25,44,45,46]. This was mainly in relation to the generation of strong reactive oxygen species (ROS) (i.e., HO•, O2−). These oxygen species attached to the cell membrane and activated the peroxidation of the polyunsaturated phospholipid component of the cell membrane. The change in cell integrity lead to the leakage of cell components and eventual cell death. In addition, Cu doping into TiO2 can enhance antibacterial activity because Cu itself is antibacterial due to the Fenton-like reaction. Furthermore, the combination of Cu and TiO2 reduced the charge carrier recombination, resulting in an increased chance of reaction with water and oxygen to generate ROS, which were responsible for destroying the bacterial cells. Furthermore, Ansari et al. discovered that the TiO2 nanofibres were more active against Gram-negative cells than Gram-positive cells. Since E. coli is a Gram-negative bacterium, other Gram-positive bacteria (e.g., S. aureus) should be further tested to demonstrate the extent of the photokilling performance of 0.1 %wt. Cu-doped TiO2 [47].
4. Conclusions
This work illustrated an approach to improve the photocatalytic activity of TiO2 by doping with Cu2+ ranging from 0.1 to 1.0 wt%. The coupling of nanoparticles between TiO2 and Cu led to a decrease in the band gap from 3.20 eV to 3.12 eV; however, the particle sizes and specific surface areas of all the Cu-doped TiO2 samples were similar to the undoped TiO2 at approximately 10 nm and 180–182 m2/g, respectively. The enhanced photocatalytic activity of Cu-doped TiO2 nanoparticles was verified by MB degradation and E. coli photokilling. The greatest photocatalytic activity was observed in the 0.1 wt.% Cu-doped TiO2 nanoparticles, which showed approximately 100% MB degradation and E. coli photokilling. However, the fraction of Cu doping significantly impacted the surface charge together with charge transfer for HO• generation, resulting in a decrease in the photocatalytic activity of 1.0 wt.% Cu-doped TiO2 nanoparticles. Therefore, the optimal fraction of metal doping was an important factor for enhancing the photocatalytic activity of TiO2.
Author Contributions
Conceptualization, W.K.; methodology, K.R., A.N. and W.K.; validation, D.C., K.R., A.N. and W.K.; formal analysis, Y.M., D.T.T.T., P.P. and, K.R; investigation, Y.M., P.P. and K.R.; resources, K.R., A.N. and W.K.; data curation, Y.M. and P.P.; writing—original draft preparation, Y.M. and W.K.; supervision, A.N. and W.K.; project administration; All authors have read and agreed to the published version of the manuscript.
Funding
This research was funded by Thailand Science Research and Innovation (TSRI) through project R2565B038. The APC was partially supported by Naresuan University and TSRI (Project No. R2565B038).
Institutional Review Board Statement
Not applicable.
Informed Consent Statement
Not applicable.
Data Availability Statement
Not applicable.
Acknowledgments
This work was supported by Thailand Science Research and Innovation (TSRI) though project R2565B038.
Conflicts of Interest
The authors declare no conflict of interest.
References
- Kumaravel, V.; Nair, K.M.; Mathew, S.; Bartlett, J.; Kennedy, J.E.; Manning, H.G.; Whelan, B.J.; Leyland, N.S.; Pillai, S.C. Antimicrobial TiO2 nanocomposite coatings for surfaces, dental and orthopaedic implants. Chem. Eng. J. 2021, 416, 129071. [Google Scholar] [CrossRef] [PubMed]
- Liu, H.; Feng, Y.; Shao, J.; Chen, Y.; Wang, Z.L.; Li, H.; Chen, X.; Bian, Z. Self-cleaning triboelectric nanogenerator based on TiO2 photocatalysis. Nano Energy 2020, 70, 104499. [Google Scholar] [CrossRef]
- Threrujirapapong, T.; Khanitchaidecha, W.; Nakaruk, A. Treatment of high organic carbon industrial wastewater using photocatalysis process. Environ. Nanotechnol. Monit. Manag. 2017, 8, 163–168. [Google Scholar] [CrossRef]
- Kaur, N.; Mahajan, A.; Bhullar, V.; Singh, D.P.; Saxena, V.; Debnath, A.K.; Aswal, D.K.; Devi, D.; Singh, F.; Chopra, S. Ag ion implanted TiO2 photoanodes for fabrication of highly efficient and economical plasmonic dye sensitized solar cells. Chem. Phys. Lett. 2020, 740, 137070. [Google Scholar] [CrossRef]
- Geppert, M.; Schwarz, A.; Stangassinger, L.M.; Wenger, S.; Wienerroither, L.M.; Ess, S.; Duschl, A.; Himly, M. Interactions of TiO2 Nanoparticles with Ingredients from Modern Lifestyle Products and Their Effects on Human Skin Cells. Chem. Res. Toxicol. 2020, 33, 1215–1225. [Google Scholar] [CrossRef] [Green Version]
- Cheung, K.H.; Pabbruwe, M.B.; Chen, W.-F.; Koshy, P.; Sorrell, C.C. Thermodynamic and microstructural analyses of photocatalytic TiO2 from the anodization of biomedical-grade Ti6Al4V in phosphoric acid or sulfuric acid. Ceram. Int. 2021, 47, 1609–1624. [Google Scholar] [CrossRef]
- Kordjazi, Z.; Ajji, A. Development of TiO2 catalyzed HTPB based oxygen scavenging films for food packaging applications. Food Control 2021, 121, 107639. [Google Scholar] [CrossRef]
- Yemmireddy, V.K.; Hung, Y.-C. Using Photocatalyst Metal Oxides as Antimicrobial Surface Coatings to Ensure Food Safety—Opportunities and Challenges. Compr. Rev. Food Sci. Food Saf. 2017, 16, 617–631. [Google Scholar] [CrossRef] [Green Version]
- Dudefoi, W.; Moniz, K.; Allen-Vercoe, E.; Ropers, M.-H.; Walker, V.K. Impact of food grade and nano-TiO2 particles on a human intestinal community. Food Chem. Toxicol. 2017, 106, 242–249. [Google Scholar] [CrossRef]
- Kusmierek, E. A CeO2 Semiconductor as a Photocatalytic and Photoelectrocatalytic Material for the Remediation of Pollutants in Industrial Wastewater: A Review. Catalysts 2020, 10, 1435. [Google Scholar] [CrossRef]
- Trinh, D.T.T.; Channei, D.; Nakaruk, A.; Khanitchaidecha, W. New insight into the photocatalytic degradation of organic pollutant over BiVO4/SiO2/GO nanocomposite. Sci. Rep. 2021, 11, 4620. [Google Scholar] [CrossRef] [PubMed]
- Prashad Ojha, D.; Babu Poudel, M.; Joo Kim, H. Investigation of electrochemical performance of a high surface area mesoporous Mn doped TiO2 nanoparticle for a supercapacitor. Mater. Lett. 2020, 264, 127363. [Google Scholar] [CrossRef]
- Lim, J.; Yang, Y.; Hoffmann, M.R. Activation of Peroxymonosulfate by Oxygen Vacancies-Enriched Cobalt-Doped Black TiO2 Nanotubes for the Removal of Organic Pollutants. Environ. Sci. Technol. 2019, 53, 6972–6980. [Google Scholar] [CrossRef] [PubMed] [Green Version]
- Alotaibi, A.M.; Promdet, P.; Hwang, G.B.; Li, J.; Nair, S.P.; Sathasivam, S.; Kafizas, A.; Carmalt, C.J.; Parkin, I.P. Zn and N Codoped TiO2 Thin Films: Photocatalytic and Bactericidal Activity. ACS Appl. Mater. Interfaces 2021, 13, 10480–10489. [Google Scholar] [CrossRef]
- Moon, E.W.; Lee, H.-W.; Rok, J.H.; Ha, J.-H. Photocatalytic inactivation of viral particles of human norovirus by Cu-doped TiO2 non-woven fabric under UVA-LED wavelengths. Sci. Total Environ. 2020, 749, 141574. [Google Scholar] [CrossRef]
- Mathew, S.; Ganguly, P.; Rhatigan, S.; Kumaravel, V.; Byrne, C.; Hinder, S.J.; Bartlett, J.; Nolan, M.; Pillai, S.C. Cu-Doped TiO2: Visible Light Assisted Photocatalytic Antimicrobial Activity. Appl. Sci. 2018, 8, 2067. [Google Scholar] [CrossRef] [Green Version]
- Karunakaran, C.; Abiramasundari, G.; Gomathisankar, P.; Manikandan, G.; Anandi, V. Cu-doped TiO2 nanoparticles for photocatalytic disinfection of bacteria under visible light. J. Colloid Interface Sci. 2010, 352, 68–74. [Google Scholar] [CrossRef]
- Yang, X.-j.; Wang, S.; Sun, H.-m.; Wang, X.-b.; Lian, J.-S. Preparation and photocatalytic performance of Cu-doped TiO2 nanoparticles. Trans. Nonferrous Met. Soc. China 2015, 25, 504–509. [Google Scholar] [CrossRef]
- Wu, B.; Huang, R.; Sahu, M.; Feng, X.; Biswas, P.; Tang, Y.J. Bacterial responses to Cu-doped TiO2 nanoparticles. Sci. Total Environ. 2010, 408, 1755–1758. [Google Scholar] [CrossRef]
- Aguilar, T.; Navas, J.; Alcántara, R.; Fernández-Lorenzo, C.; Gallardo, J.J.; Blanco, G.; Martín-Calleja, J. A route for the synthesis of Cu-doped TiO2 nanoparticles with a very low band gap. Chem. Phys. Lett. 2013, 571, 49–53. [Google Scholar] [CrossRef]
- Choudhury, B.; Dey, M.; Choudhury, A. Defect generation, d-d transition, and band gap reduction in Cu-doped TiO2 nanoparticles. Int. Nano Lett. 2013, 3, 25. [Google Scholar] [CrossRef] [Green Version]
- Pongwan, P.; Wetchakun, K.; Phanichphant, S.; Wetchakun, N. Enhancement of visible-light photocatalytic activity of Cu-doped TiO2 nanoparticles. Res. Chem. Intermed. 2016, 42, 2815–2830. [Google Scholar] [CrossRef]
- Geesi, M.H.; Ouerghi, O.; Elsanousi, A.; Kaiba, A.; Riadi, Y. Ultrasound-Assisted Preparation of Cu-Doped TiO2 Nanoparticles as a Nanocatalyst for Sonochemical Synthesis of Pyridopyrimidines. Polycycl. Aromat. Compd. 2022, 42, 80–90. [Google Scholar] [CrossRef]
- Zhu, X.; Wen, G.; Liu, H.; Han, S.; Chen, S.; Kong, Q.; Feng, W. One-step hydrothermal synthesis and characterization of Cu-doped TiO2 nanoparticles/nanobucks/nanorods with enhanced photocatalytic performance under simulated solar light. J. Mater. Sci. Mater. Electron. 2019, 30, 13826–13834. [Google Scholar] [CrossRef]
- Sunada, K.; Watanabe, T.; Hashimoto, K. Studies on photokilling of bacteria on TiO2 thin film. J. Photochem. Photobiol. A Chem. 2003, 156, 227–233. [Google Scholar] [CrossRef]
- Li, G.; Dimitrijevic, N.M.; Chen, L.; Rajh, T.; Gray, K.A. Role of Surface/Interfacial Cu2+ Sites in the Photocatalytic Activity of Coupled CuO−TiO2 Nanocomposites. J. Phys. Chem. C 2008, 112, 19040–19044. [Google Scholar] [CrossRef]
- Irie, H.; Miura, S.; Kamiya, K.; Hashimoto, K. Efficient visible light-sensitive photocatalysts: Grafting Cu(II) ions onto TiO2 and WO3 photocatalysts. Chem. Phys. Lett. 2008, 457, 202–205. [Google Scholar] [CrossRef]
- Tamarani, A.; Zainul, R.; Dewata, I. Preparation and characterization of XRD nano Cu-TiO2 using sol-gel method. J. Phys. Conf. Ser. 2019, 1185, 012020. [Google Scholar] [CrossRef]
- Souvereyns, B.; Elen, K.; De Dobbelaere, C.; Kelchtermans, A.; Peys, N.; D’Haen, J.; Mertens, M.; Mullens, S.; Van den Rul, H.; Meynen, V.; et al. Hydrothermal synthesis of a concentrated and stable dispersion of TiO2 nanoparticles. Chem. Eng. J. 2013, 223, 135–144. [Google Scholar] [CrossRef]
- Sirichokthanasarp, J.; Trinh, D.T.T.; Channei, D.A.D.; Chansaenpak, K.; Khanitchaidecha, W.; Nakaruk, A. Influence of Preparation Methods of TiO2 Nano-Particle on Photodegradation of Methylene Blue. Mater. Sci. Forum 2020, 998, 84–89. [Google Scholar] [CrossRef]
- Zhou, X.; Zhang, X.; Wang, Y.; Wu, Z. 2D Graphene-TiO2 Composite and Its Photocatalytic Application in Water Pollutants. Front. Energy Res. 2021, 8, 6122512. [Google Scholar] [CrossRef]
- Fernández-Catalá, J.; Sánchez-Rubio, M.; Navlani-García, M.; Berenguer-Murcia, Á.; Cazorla-Amorós, D. Synthesis of TiO2/Nanozeolite Composites for Highly Efficient Photocatalytic Oxidation of Propene in the Gas Phase. ACS Omega 2020, 5, 31323–31331. [Google Scholar] [CrossRef] [PubMed]
- Tauc, J.; Grigorovici, R.; Vancu, A. Optical Properties and Electronic Structure of Amorphous Germanium. Phys. Status Solidi B 1966, 15, 627–637. [Google Scholar] [CrossRef]
- Hanaor, D.A.H.; Sorrell, C.C. Review of the anatase to rutile phase transformation. J. Mater. Sci. 2011, 46, 855–874. [Google Scholar] [CrossRef] [Green Version]
- Shannon, R.D. Revised effective ionic radii and systematic studies of interatomic distances in halides and chalcogenides. Acta Crystallogr. A Found. Adv. 1976, 32, 751–767. [Google Scholar] [CrossRef]
- Nguyen Thi Thu, T.; Nguyen Thi, N.; Tran Quang, V.; Nguyen Hong, K.; Nguyen Minh, T.; Le Thi Hoai, N. Synthesis, characterisation, and effect of pH on degradation of dyes of copper-doped TiO2. J. Exp. Nanosci. 2016, 11, 226–238. [Google Scholar] [CrossRef] [Green Version]
- Krishnakumar, V.; Boobas, S.; Jayaprakash, J.; Rajaboopathi, M.; Han, B.; Louhi-Kultanen, M. Effect of Cu doping on TiO2 nanoparticles and its photocatalytic activity under visible light. J. Mater. Sci. Mater. Electron. 2016, 27, 7438–7447. [Google Scholar] [CrossRef]
- Wen, L.; Liu, B.; Zhao, X.; Nakata, K.; Murakami, T.; Fujishima, A. Synthesis, Characterization, and Photocatalysis of Fe-Doped TiO2: A Combined Experimental and Theoretical Study. Int. J. Photoenergy 2012, 2012, 368750. [Google Scholar] [CrossRef]
- Moradi, H.; Eshaghi, A.; Hosseini, S.R.; Ghani, K. Fabrication of Fe-doped TiO2 nanoparticles and investigation of photocatalytic decolorization of reactive red 198 under visible light irradiation. Ultrason. Sonochem. 2016, 32, 314–319. [Google Scholar] [CrossRef]
- Zhang, Z.; Wang, C.-C.; Zakaria, R.; Ying, J.Y. Role of Particle Size in Nanocrystalline TiO2-Based Photocatalysts. J. Phys. Chem. B 1998, 102, 10871–10878. [Google Scholar] [CrossRef]
- Qiu, X.; Miyauchi, M.; Sunada, K.; Minoshima, M.; Liu, M.; Lu, Y.; Li, D.; Shimodaira, Y.; Hosogi, Y.; Kuroda, Y.; et al. Hybrid CuxO/TiO2 Nanocomposites as Risk-Reduction Materials in Indoor Environments. ACS Nano 2012, 6, 1609–1618. [Google Scholar] [CrossRef] [PubMed]
- Gamage McEvoy, J.; Zhang, Z. Antimicrobial and photocatalytic disinfection mechanisms in silver-modified photocatalysts under dark and light conditions. J. Photochem. Photobiol. C Photochem. Rev. 2014, 19, 62–75. [Google Scholar] [CrossRef]
- Janczarek, M.; Endo, M.; Zhang, D.; Wang, K.; Kowalska, E. Enhanced Photocatalytic and Antimicrobial Performance of Cuprous Oxide/Titania: The Effect of Titania Matrix. Materials 2018, 11, 2069. [Google Scholar] [CrossRef] [PubMed] [Green Version]
- Applerot, G.; Lellouche, J.; Lipovsky, A.; Nitzan, Y.; Lubart, R.; Gedanken, A.; Banin, E. Understanding the Antibacterial Mechanism of CuO Nanoparticles: Revealing the Route of Induced Oxidative Stress. Small 2012, 8, 3326–3337. [Google Scholar] [CrossRef] [PubMed]
- Othman, S.H.; Abd Salam, N.R.; Zainal, N.; Kadir Basha, R.; Talib, R.A. Antimicrobial Activity of TiO2 Nanoparticle-Coated Film for Potential Food Packaging Applications. Int. J. Photoenergy 2014, 2014, 945930. [Google Scholar] [CrossRef] [Green Version]
- Meghana, S.; Kabra, P.; Chakraborty, S.; Padmavathy, N. Understanding the pathway of antibacterial activity of copper oxide nanoparticles. RSC Adv. 2015, 5, 12293–12299. [Google Scholar] [CrossRef]
- Ansari, M.A.; Albetran, H.M.; Alheshibri, M.H.; Timoumi, A.; Algarou, N.A.; Akhtar, S.; Slimani, Y.; Almessiere, M.A.; Alahmari, F.S.; Baykal, A.; et al. Synthesis of Electrospun TiO2 Nanofibers and Characterization of Their Antibacterial and Antibiofilm Potential against Gram-Positive and Gram-Negative Bacteria. Antibiotics 2020, 9, 572. [Google Scholar] [CrossRef] [PubMed]
Publisher’s Note: MDPI stays neutral with regard to jurisdictional claims in published maps and institutional affiliations. |
© 2022 by the authors. Licensee MDPI, Basel, Switzerland. This article is an open access article distributed under the terms and conditions of the Creative Commons Attribution (CC BY) license (https://creativecommons.org/licenses/by/4.0/).